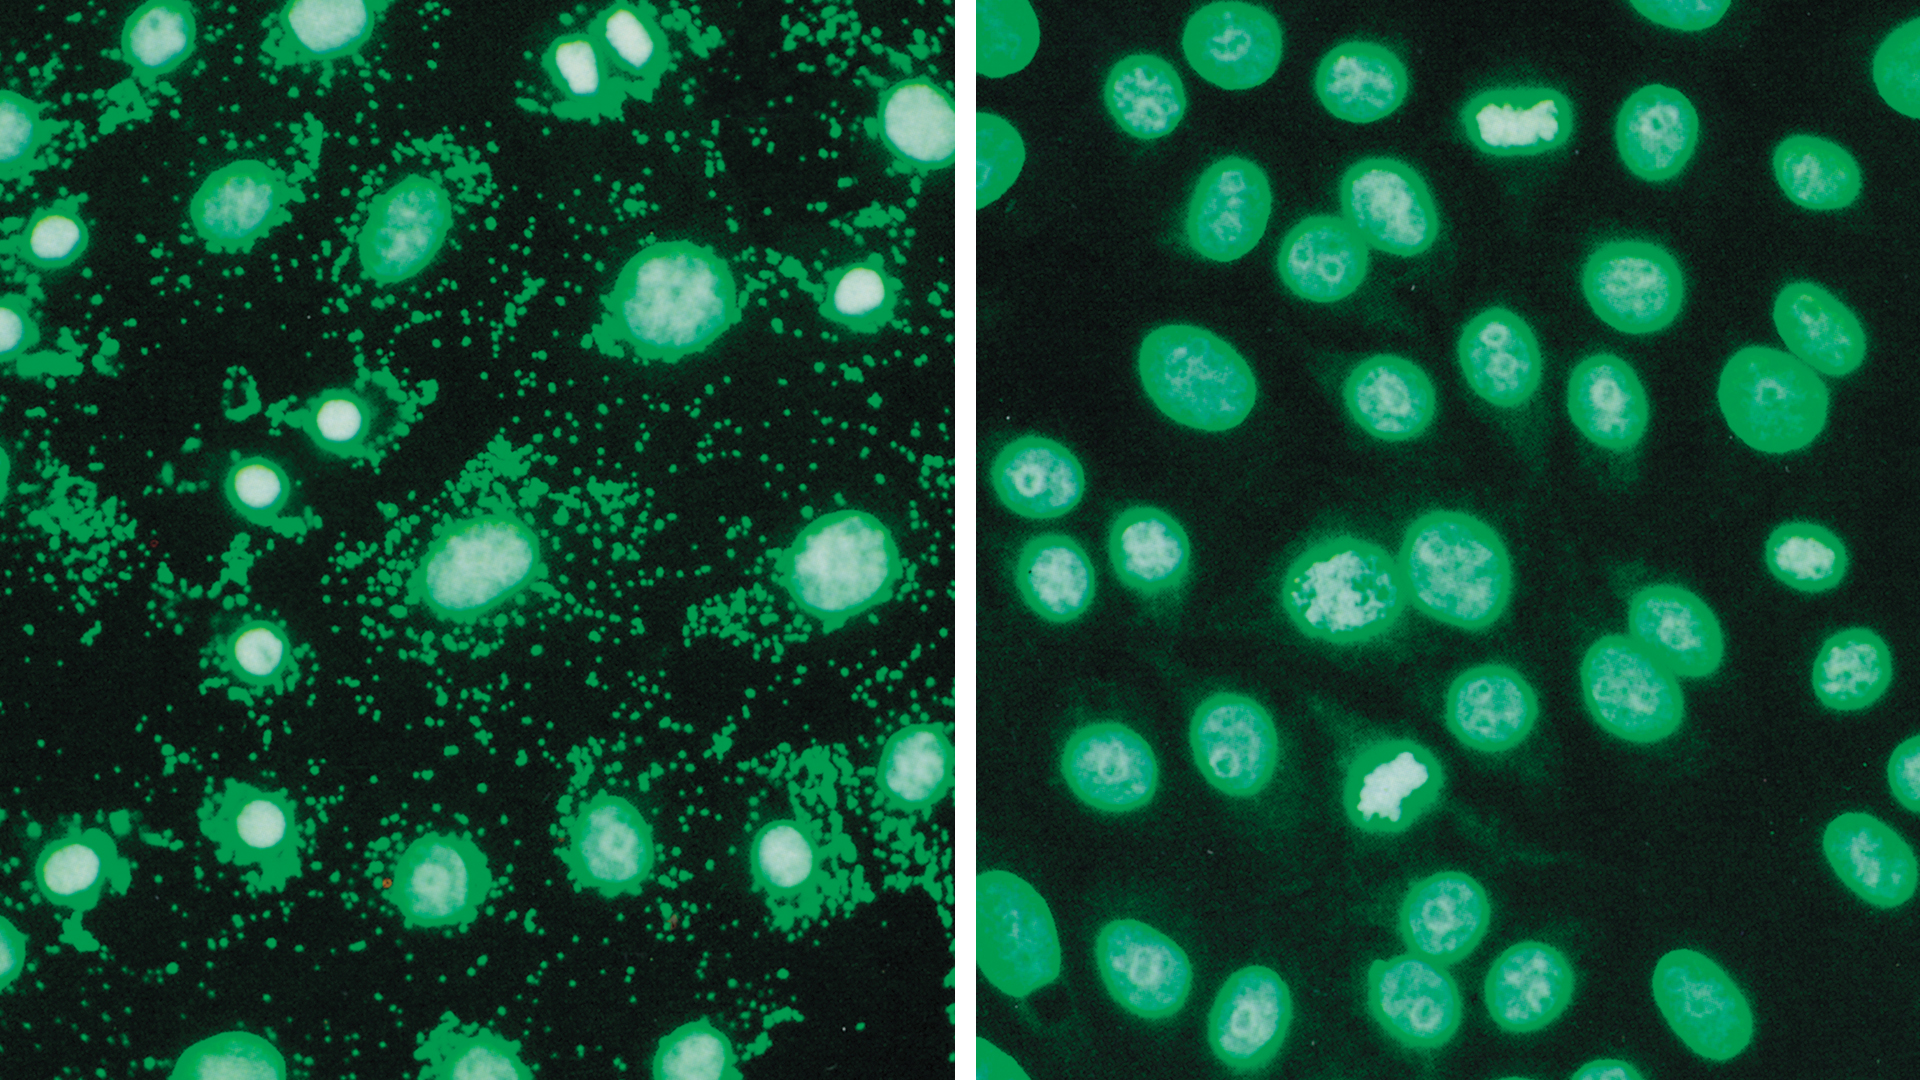

Woman concerned about cell culture contamination.

-
Facts! -
Hearsay! -
Towels!



The Answer to the Ultimate Question:
-5
Critical
Less Critical
Critical
Towels
Less Critical
Pizza
Correct answers
42%
So long! And thanks for all the fish!

Mr. Porpoise
Swimmer
Advice 3
Make way for the galactic highway!
All you need is a towel.
Buy an intergalactic gargle blaster.
Catastrophe Alert!
Move or be bulldozed/




